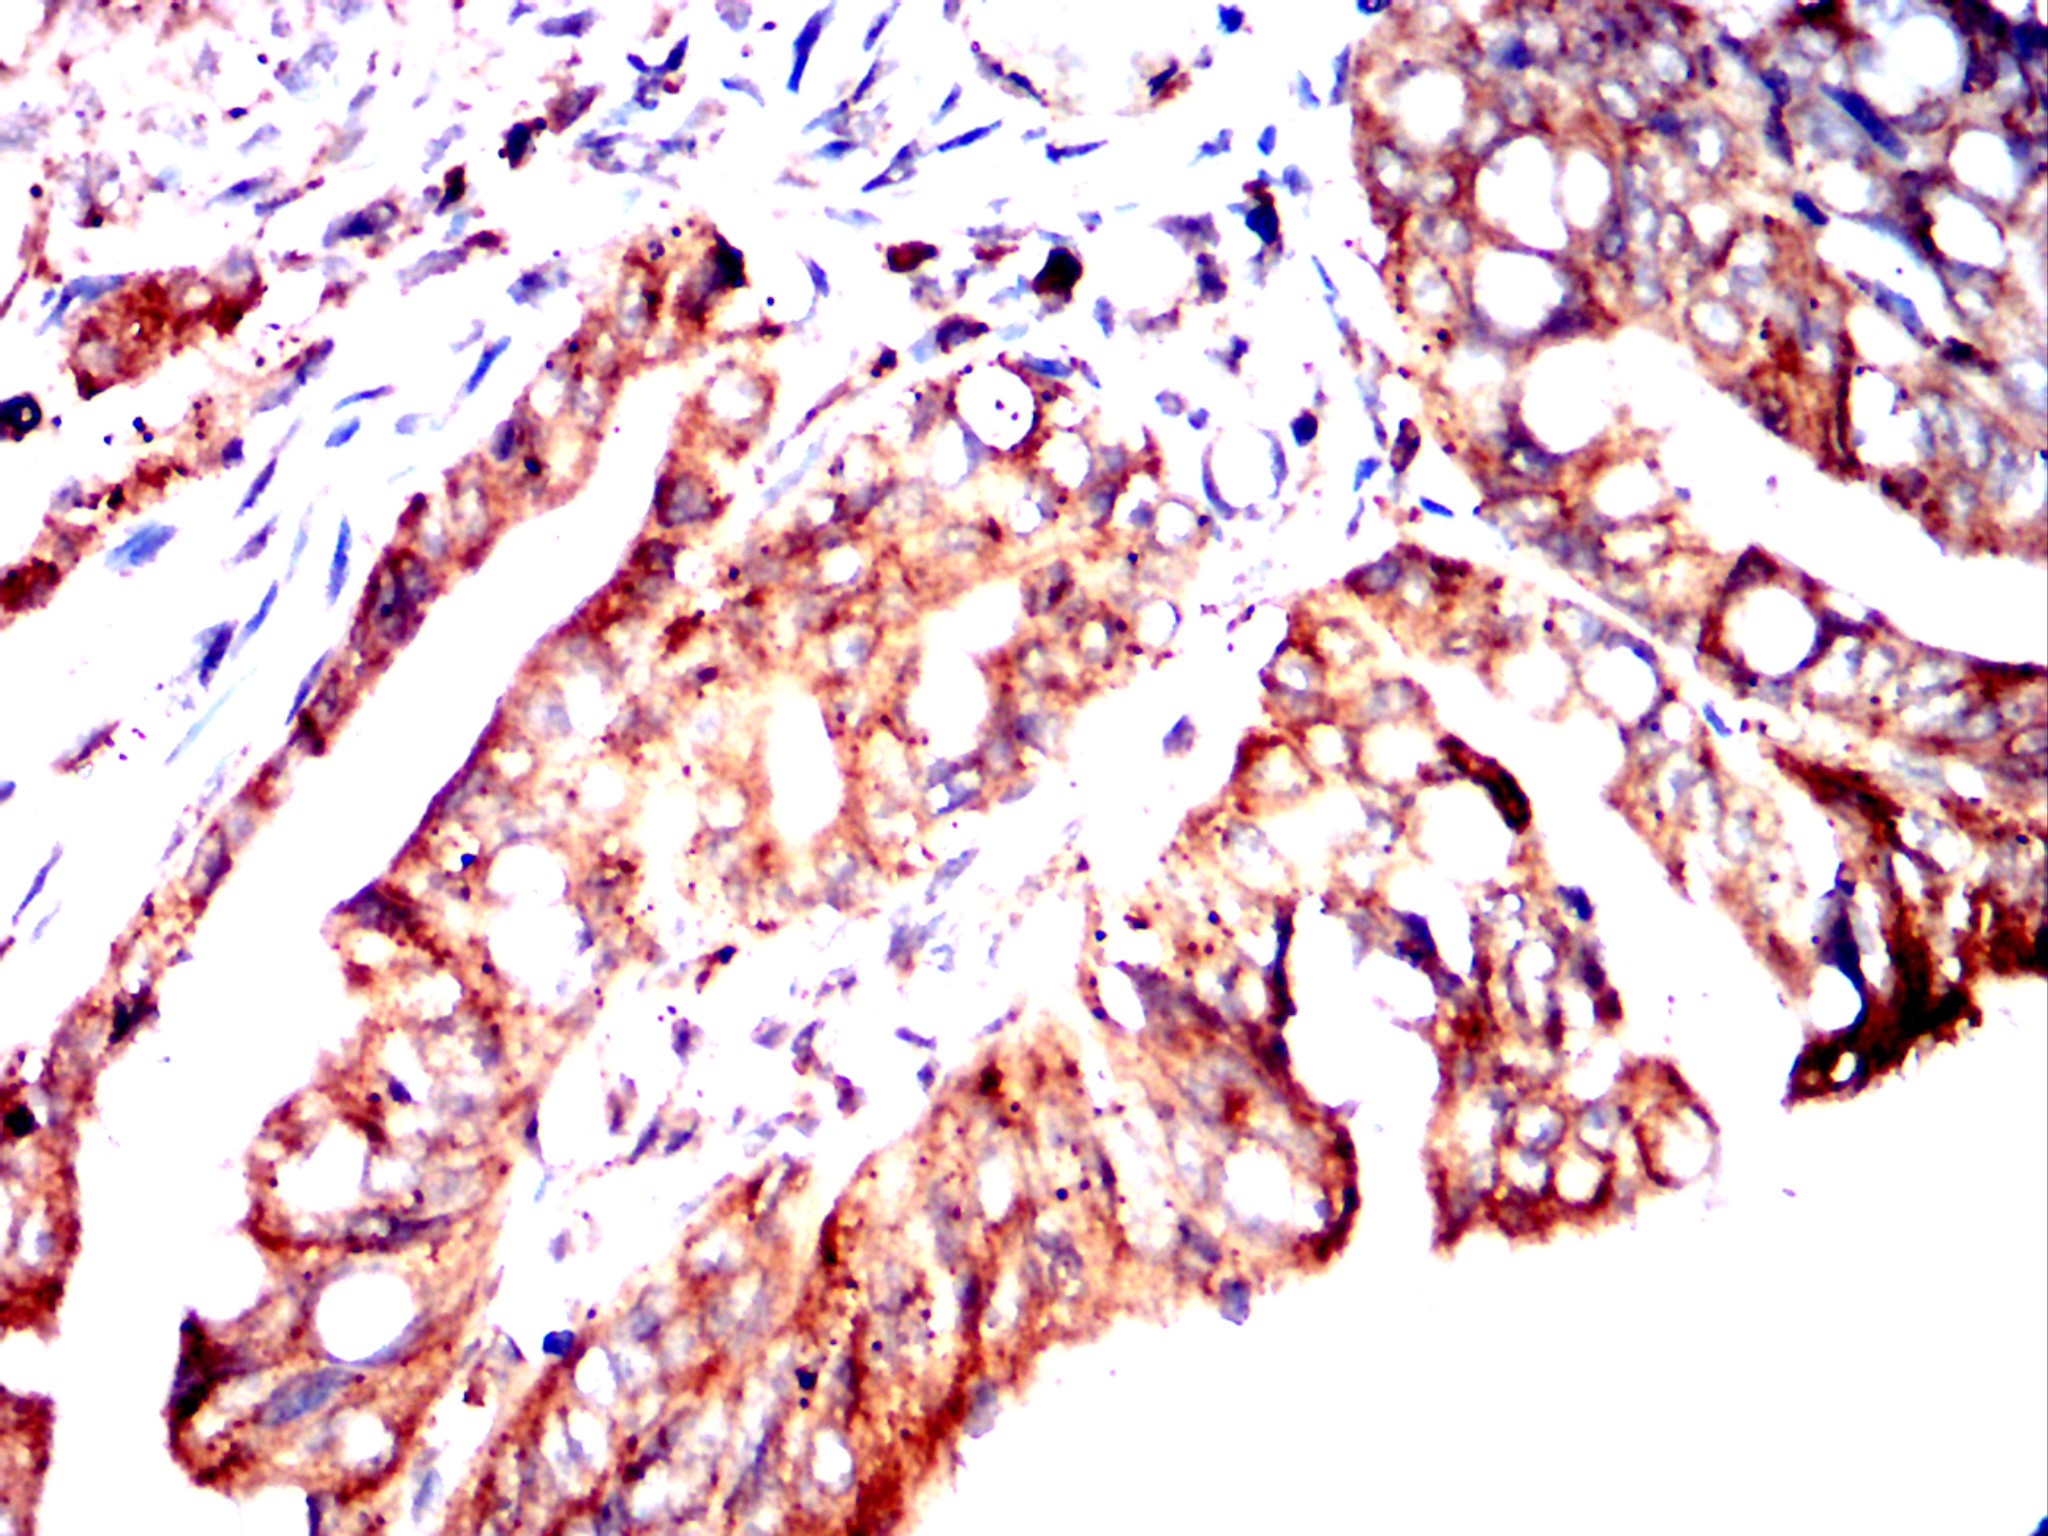

Mouse Monoclonal Antibody to CHRM3
货号:
32452
别名:
HM3;PBS;EGBRS;m3AChR
应用:
IHC,IF,FCM
反应种属:
Human,Mouse,Rabbit
抗体类型:
Primary antibody
Swissprot:
P20309
规格:
目录价
在线咨询
Description |
|---|
The muscarinic cholinergic receptors belong to a larger family of G protein-coupled receptors. The functional diversity of these receptors is defined by the binding of acetylcholine and includes cellular responses such as adenylate cyclase inhibition, phosphoinositide degeneration, and potassium channel mediation. Muscarinic receptors influence many effects of acetylcholine in the central and peripheral nervous system. The muscarinic cholinergic receptor 3 controls smooth muscle contraction and its stimulation causes secretion of glandular tissue. Alternative promoter use and alternative splicing results in multiple transcript variants that have different tissue specificities. [provided by RefSeq, Dec 2016] |
References |
|---|
| Homodimer; the dimers can form tetramers (PubMed:23521066). |
Specification |
|
|---|---|
| Aliases | HM3;PBS;EGBRS;m3AChR |
| Entrez GeneID | 1131 |
| Swissprot | P20309 |
| clone | 3G6D10 |
| WB Predicted band size | 66kDa |
| Host/Isotype | Mouse IgG2a |
| Antibody Type | Primary antibody |
| Storage | Store at 4°C short term. Aliquot and store at -20°C long term. Avoid freeze/thaw cycles. |
| Species Reactivity | Human,Mouse,Rabbit |
| Formulation | Purified antibody in PBS with 0.05% sodium azide |
Application |
|
|---|---|
| IHC | 1/200-1/400 |
| IF | 1/25-1/50 |
| FCM | 1/200 - 1/400 |
Product Image
-
Confocal Immunofluorescence analysis of NIH3T3 cells using CHRM3 mouse mAb (green). Red: Actin filaments have been labeled with Alexa Fluor-555 phalloidin. Blue: DRAQ5 fluorescent DNA dye.

-
Flow cytometric analysis of SK-BR-3 cells using CHRM3 mouse mAb (green) and negative control (red).

-
Flow cytometric analysis of SK-N-SH cells using CHRM3 mouse mAb (green) and negative control (red).

-
Immunohistochemical analysis of paraffin-embedded human cervical cancer tissues using CHRM3 mouse mAb with DAB staining.

-
Immunohistochemical analysis of paraffin-embedded human rectal cancer tissues using CHRM3 mouse mAb with DAB staining.

-
Immunohistochemical analysis of paraffin-embedded mouse liver tissues using CHRM3 mouse mAb with DAB staining.

-
Immunohistochemical analysis of paraffin-embedded rabbit liver tissues using CHRM3 mouse mAb with DAB staining.

-
Immunohistochemical analysis of paraffin-embedded rabbit kidney tissues using CHRM3 mouse mAb with DAB staining.

鄂公网安备42018502007531号
鄂公网安备42018502007531号

